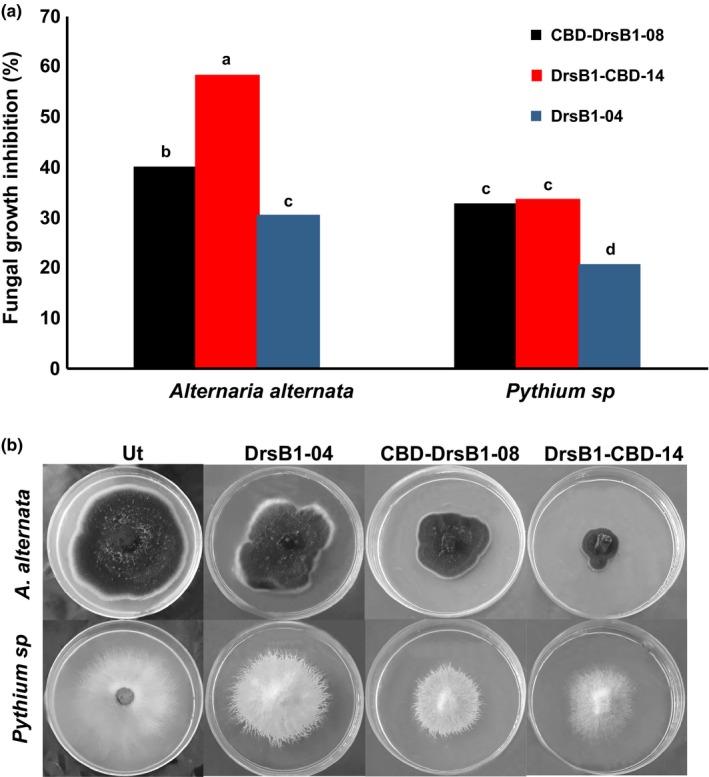
https://cdn.ncbi.nlm.nih.gov/pmc/blobs/ef07/6854847/cddc1017034c/MBO3-8-e837-g004.jpg
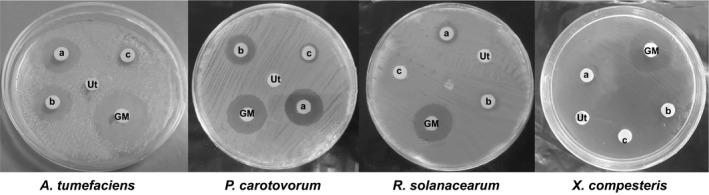
https://cdn.ncbi.nlm.nih.gov/pmc/blobs/ef07/6854847/74961726b754/MBO3-8-e837-g003.jpg

通过在烟草中表达新的重组抗菌肤肽来靶向微生物病原体。
Targeting microbial pathogens by expression of new recombinant dermaseptin peptides in tobacco.
机构信息
Agronomy and Plant Breeding Department, Faculty of Agriculture, Lorestan University, Khorramabad, Iran.
Agricultural Biotechnology Department, Faculty of Agricultural Sciences, University of Guilan, Rasht, Iran.
出版信息
Microbiologyopen. 2019 Nov;8(11):e837. doi: 10.1002/mbo3.837. Epub 2019 Mar 25.
Dermaseptin B1 (DrsB1), an antimicrobial cationic 31 amino acid peptide, is produced by Phyllomedusa bicolor. In an attempt to enhance the antimicrobial efficacy of DrsB1, the DrsB1 encoding 93 bp sequence was either fused to the N or C terminus of sequence encoding chitin-binding domain (CBD) of Avr4 gene from Cladosporium fulvum. Tobacco leaf disk explants were inoculated with Agrobacterium rhizogenes harboring pGSA/CBD-DrsB1 and pGSA/DrsB1-CBD expression vectors to produce hairy roots (HRs). Polymerase chain reaction (PCR) was employed to screen putative transgenic tobacco lines. Semi-quantitative RT-PCR and western blotting analysis indicated that the expression of recombinant genes were significantly higher, and recombinant proteins were produced in transgenic HRs. The recombinant proteins were extracted from the tobacco HRs and used against Pectobacterium carotovorum, Agrobacterium tumefaciens, Ralstonia solanacearum, and Xanthomonas campestris pathogenic bacteria and Alternaria alternata and Pythium sp. fungi. Two recombinant proteins had a statistically significant (p < 0.01) inhibitory effect on the growth and development of plant pathogens. The CBD-DrsB1 recombinant protein demonstrated a higher antibacterial effect, whereas the DrsB1-CBD recombinant protein demonstrated greater antifungal activity. Scanning electron microscopy images revealed that the structure of the fungal mycelia appeared segmented, adhered to each other, and crushed following the antimicrobial activity of the recombinant proteins. Due to the high antimicrobial activity of the recombinant proteins against plant pathogens, this strategy can be used to generate stable transgenic crop plants resistant to devastating plant pathogens.
抗菌肽 Dermaseptin B1(DrsB1)是由双色 Phyllomedusa 产生的一种 31 个氨基酸的阳离子抗菌肽。为了增强 DrsB1 的抗菌效果,将编码 93 bp 序列的 DrsB1 编码序列融合到来自 Cladosporium fulvum 的几丁质结合域(CBD)编码序列的 N 或 C 末端。将携带 pGSA/CBD-DrsB1 和 pGSA/DrsB1-CBD 表达载体的根瘤农杆菌接种到烟草叶片圆盘外植体上,以产生毛状根(HRs)。采用聚合酶链反应(PCR)筛选可能的转基因烟草株系。半定量 RT-PCR 和 Western blot 分析表明,重组基因的表达显著提高,并且在转基因 HRs 中产生了重组蛋白。从烟草 HRs 中提取重组蛋白,并用于对抗果胶杆菌、根癌农杆菌、青枯菌和野油菜黄单胞菌等病原菌,以及Alternaria alternata 和 Pythium sp.等真菌。两种重组蛋白对植物病原菌的生长和发育具有统计学显著(p < 0.01)的抑制作用。CBD-DrsB1 重组蛋白表现出更高的抑菌效果,而 DrsB1-CBD 重组蛋白表现出更强的抗真菌活性。扫描电子显微镜图像显示,真菌菌丝的结构出现分段,相互粘连,并在重组蛋白的抗菌活性作用下被压碎。由于重组蛋白对植物病原菌具有高抗菌活性,因此该策略可用于生成对破坏性植物病原菌具有抗性的稳定转基因作物。